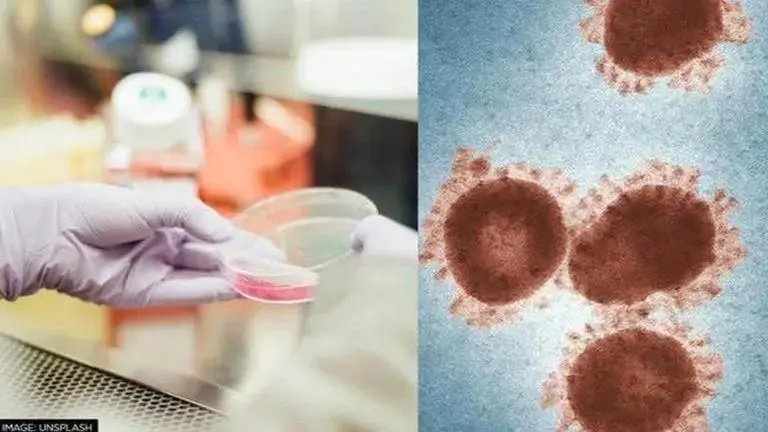
Four strange COVID-19 symptoms you might not have heard about Pandemic

Four strange COVID-19 symptoms you might not have heard about
Well over two years into the pandemic, hundreds of thousands of COVID cases continue to be recorded around the world every day.
- Lifestyle News
- 5 min read
Well over two years into the pandemic, hundreds of thousands of COVID cases continue to be recorded around the world every day.
With the rise of new variants, the symptoms of COVID have also evolved. Initially, the NHS regarded a fever, cough, and loss or change in sense of smell or taste as the main symptoms which could indicate COVID infection. Now, recently updated NHS guidance suggests also looking out for symptoms including a sore throat, blocked or runny nose, and a headache.
But what about some of the more obscure signs and symptoms? From skin lesions to hearing loss, emerging data is increasingly showing us that COVID symptoms can go beyond what you might expect from a regular cold or a flu.
1. Skin lesions COVID-related skin complaints are not uncommon. In fact, a UK study published in 2021 found that one in five patients only exhibited a rash and no other symptom.
Advertisement
COVID can affect the skin in a variety of ways. Some people may experience a widespread maculopapular rash (flat or raised areas of discoloured skin), while others might present with hives (raised areas of itchy skin).
“COVID toes”, meanwhile, describes red, swollen or blistering skin lesions on the toes. This symptom is more commonly seen in adolescents or young adults with mild or no symptoms.
Advertisement
Most COVID skin lesions tend to go away after a few days, or in some instances a few weeks, without the need for any specialised treatment. If the skin is very itchy or painful though, you can consult a GP or dermatologist, who may recommend treatment such as a cream.
2. COVID nails During an infection, including that of SARS-CoV-2 (the virus which causes COVID-19), our bodies naturally try to express that they’re under an unusual amount of stress. They can do this in a variety of weird and wonderful ways, including through our nails. “COVID nails” encompasses changes such as: Beau’s lines – horizontal indentations that occur at the base of the fingernails or toenails when there’s a temporary interruption in nail growth due to a physical stress on the body Mees’ lines – horizontal white lines that appear on the nails, thought to be caused by the abnormal production of proteins in the nail bed a red half-moon pattern which develops at the base of the fingernails (the mechanism underlying this change is unclear).
The data on how many people experience COVID nails is limited, but it’s been estimated it could be up to 1-2% of COVID patients.
COVID nails tend to appear in the days or weeks following COVID infection as the nails grow. Although they might be painful initially, the vast majority tend to return to normal over a few weeks.
Notably, while these changes may be indicative of COVID, they can also be caused by different things. For example, Beau’s lines can be secondary to chemotherapy or another infection.
Hair loss Hair loss is perhaps an understated symptom of COVID-19, usually occurring one month or more after the acute infection. In one study of almost 6,000 people who had previously had COVID, hair loss was the most common post-COVID symptom, reported by 48% of participants. It was especially prevalent among people who had severe COVID and white women.
It is thought that this results from the hair “sensing” the stress in the body, leading to excess shedding. Indeed, hair loss can also be triggered by other stressful events, such as childbirth. The good news is that with time the hair grows back to normal.
Hearing loss and tinnitus As with other viral infections, such as the flu and measles, COVID has been found to affect the cells in the inner ear, with hearing loss or tinnitus (a constant ringing sensation in the ear) sometimes following infection.
In a review study that included 560 participants, hearing loss occurred in 3.1% of patients with COVID, while tinnitus occurred in 4.5%.
In one study of 30 people who had been diagnosed with COVID, and 30 who hadn’t – none with pre-existing hearing problems – the researchers found that COVID was associated with damage to the inner ear which led to hearing impairment at higher frequencies. While for the vast majority of patients this resolves on its own, cases of permanent hearing loss linked to COVID have been reported.
Why all these symptoms? We don’t understand exactly what causes these symptoms, but we know the most important part is played by a process called inflammation. Inflammation is our body’s natural defence mechanism against pathogens; SARS-CoV-2 in this case. It involves the production of “cytokines” – proteins which are important in controlling the activity of immune cells.
Excessive production of these proteins, as a part of the inflammation triggered by COVID infection, can cause sensory deficits, which potentially explain why some people are presenting with hearing loss and tinnitus. It can also disrupt the capillary networks, very tiny blood vessels which provide blood to organs including the ears, skin and nails.
The symptoms we’ve described here are not exclusive to COVID infection. That said, if you notice any of these symptoms, it would be appropriate to consider a COVID test, especially if you’re in an area where COVID is circulating.
You can also contact your GP, particularly if the symptoms are getting worse or causing you significant discomfort. At the same time, you can be reassured that most of these symptoms are likely to improve with time.